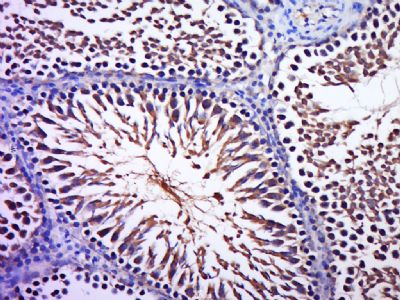
产品细节图片1

相关产品推荐更多 >
万千商家帮你免费找货
0 人在求购买到急需产品
- 详细信息
- 文献和实验
- 技术资料
- 供应商:
上海联迈生物工程有限公司
- 库存:
大量
- 目录编号:
LM-12556R
- 克隆性:
多克隆
- 抗原来源:
Rabbit
- 保质期:
1年
- 抗体英文名:
phospho-B Raf (Thr598 + Ser601)
- 抗体名:
磷酸化B-Raf抗体
- 宿主:
Rabbit
- 适应物种:
Human, Mouse, Rat, Chicken, Dog, Pig, Cow, Sheep,
- 免疫原:
KLH conjugated synthesised phosphopeptide derived from human B Raf around the phosphorylation site of Thr446 + Ser601:LA(p-T)VK(p-S)RW
- 亚型:
IgG
- 形态:
Lyophilized or Liquid
- 应用范围:
WB=1:500-2000 ELISA=1:500-1000 IHC-P=1:400-800 IHC-F=1:400-800 ICC=1:100-500 IF=1:100-500 (石蜡切片需做抗原修复)
- 浓度:
1mg/ml
- 保存条件:
Store at -20 °C
- 规格:
100ul
| 英文名称 | phospho-B Raf (Thr598 + Ser601) |
| 中文名称 | 磷酸化B-Raf抗体 |
| 别 名 | B Raf (phospho T598 + S601); p-B Raf (phospho T598 + S601); 94 kDa B raf protein; B raf 1; B Raf proto oncogene serine threonine protein kinase; BRAF 1; Braf; BRAF1; cRmil; MGC126806; MGC138284; Murine sarcoma viral (v-raf) oncogene homolog B1; Murine sarcoma viral v raf oncogene homolog B1; p94; RAFB 1; RAFB1; v raf murine sarcoma viral oncogene homolog B1; FLJ95109; BRAF_HUMAN. |
| 规格价格 | 100ul/1580元 购买 大包装/询价 |
| 说 明 书 | 100ul |
| 产品类型 | 磷酸化抗体 |
| 研究领域 | 肿瘤 细胞生物 免疫学 神经生物学 信号转导 细胞周期蛋白 转录调节因子 激酶和磷酸酶 |
| 抗体来源 | Rabbit |
| 克隆类型 | Polyclonal |
| 交叉反应 | Human, Mouse, Rat, Chicken, Dog, Pig, Cow, Sheep, |
| 产品应用 | WB=1:500-2000 ELISA=1:500-1000 IHC-P=1:400-800 IHC-F=1:400-800 ICC=1:100-500 IF=1:100-500 (石蜡切片需做抗原修复) not yet tested in other applications. optimal dilutions/concentrations should be determined by the end user. |
| 分 子 量 | 94kDa |
| 细胞定位 | 细胞核 细胞浆 细胞膜 |
| 性 状 | Lyophilized or Liquid |
| 浓 度 | 1mg/ml |
| 免 疫 原 | KLH conjugated synthesised phosphopeptide derived from human B Raf around the phosphorylation site of Thr446 + Ser601:LA(p-T)VK(p-S)RW |
| 亚 型 | IgG |
| 纯化方法 | affinity purified by Protein A |
| 储 存 液 | 0.01M TBS(pH7.4) with 1% BSA, 0.03% Proclin300 and 50% Glycerol. |
| 保存条件 | Store at -20 °C for one year. Avoid repeated freeze/thaw cycles. The lyophilized antibody is stable at room temperature for at least one month and for greater than a year when kept at -20°C. When reconstituted in sterile pH 7.4 0.01M PBS or diluent of antibody the antibody is stable for at least two weeks at 2-4 °C. |
| PubMed | PubMed |
| 产品介绍 | background: The Raf kinases are important intermediates in signal transduction. Raf protein family members, including A Raf and B Raf, have intrinsic serine/threonine kinase activity. Interaction between Ras proteins and Raf proteins results in Raf-mediated phosphorylation and activation of MEK (also known as MAP kinase kinase). Defects in BRAF are involved in a wide range of cancers. B-Raf is a serine/threonine protein kinase that acts as a signal transducer from membrane-associated receptors to nuclear transcription factors. 1 BRAF is important for the regulation of cell proliferation and determination of cell fate during embryogenesis. BRAF acts downstream of Ras and upstream of MEK in the Ras-Raf-MEK-ERK signal transduction pathway, which is a conserved RAS-activated protein kinase cascade that regulates cell growth, proliferation, and differentiation in response to growth factors, cytokines, and hormones. Function: Involved in the transduction of mitogenic signals from the cell membrane to the nucleus. May play a role in the postsynaptic responses of hippocampal neuron. Subunit: Monomer. Homodimer. Heterodimerizes with RAF1, and the heterodimer possesses a highly increased kinase activity compared to the respective homodimers or monomers. Heterodimerization is mitogen-regulated and enhanced by 14-3-3 proteins. MAPK1/ERK2 activation can induce a negative feedback that promotes the dissociation of the heterodimer by phosphorylating BRAF at Thr-753. Found in a complex with at least BRAF, HRAS1, MAP2K1, MAPK3 and RGS14. Interacts with RIT1. Interacts (via N-terminus) with RGS14 (via RBD domains); the interaction mediates the formation of a ternary complex with RAF1, a ternary complex inhibited by GNAI1 (By similarity). Interacts with DGKH. Subcellular Location: Nucleus. Cytoplasm. Cell membrane. Tissue Specificity: Brain and testis. Post-translational modifications: Phosphorylation at Ser-365 by SGK1 inhibits its activity. Methylation at Arg-671 decreases stability and kinase activity. Ubiquitinated by RNF149; which leads to proteasomal degradation. DISEASE: Note=Defects in BRAF are found in a wide range of cancers. Defects in BRAF may be a cause of colorectal cancer (CRC) [MIM:114500]. Defects in BRAF are involved in lung cancer (LNCR) [MIM:211980]. LNCR is a common malignancy affecting tissues of the lung. The most common form of lung cancer is non-small cell lung cancer (NSCLC) that can be divided into 3 major histologic subtypes: squamous cell carcinoma, adenocarcinoma, and large cell lung cancer. NSCLC is often diagnosed at an advanced stage and has a poor prognosis. Defects in BRAF are involved in non-Hodgkin lymphoma (NHL) [MIM:605027]. NHL is a cancer that starts in cells of the lymph system, which is part of the body's immune system. NHLs can occur at any age and are often marked by enlarged lymph nodes, fever and weight loss. Defects in BRAF are a cause of cardiofaciocutaneous syndrome (CFC syndrome) [MIM:115150]; also known as cardio-facio-cutaneous syndrome. CFC syndrome is characterized by a distinctive facial appearance, heart defects and mental retardation. Heart defects include pulmonic stenosis, atrial septal defects and hypertrophic cardiomyopathy. Some affected individuals present with ectodermal abnormalities such as sparse, friable hair, hyperkeratotic skin lesions and a generalized ichthyosis-like condition. Typical facial features are similar to Noonan syndrome. They include high forehead with bitemporal constriction, hypoplastic supraorbital ridges, downslanting palpebral fissures, a depressed nasal bridge, and posteriorly angulated ears with prominent helices. The inheritance of CFC syndrome is autosomal dominant. Defects in BRAF are the cause of Noonan syndrome type 7 (NS7) [MIM:613706]. Noonan syndrome is a disorder characterized by facial dysmorphic features such as hypertelorism, a downward eyeslant and low-set posteriorly rotated ears. Other features can include short stature, a short neck with webbing or redundancy of skin, cardiac anomalies, deafness, motor delay and variable intellectual deficits. Defects in BRAF are the cause of LEOPARD syndrome type 3 (LEOPARD3) [MIM:613707]. LEOPARD3 is a disorder characterized by lentigines, electrocardiographic conduction abnormalities, ocular hypertelorism, pulmonic stenosis, abnormalities of genitalia, retardation of growth, and sensorineural deafness. Similarity: Belongs to the protein kinase superfamily. TKL Ser/Thr protein kinase family. RAF subfamily. Contains 1 phorbol-ester/DAG-type zinc finger. Contains 1 protein kinase domain. Contains 1 RBD (Ras-binding) domain. SWISS: P15056 Gene ID: 673 Database links: Entrez Gene: 673 Human Entrez Gene: 109880 Mouse Entrez Gene: 114486 Rat Omim: 164757 Human SwissProt: P15056 Human SwissProt: P28028 Mouse Unigene: 550061 Human Unigene: 245513 Mouse Important Note: This product as supplied is intended for research use only, not for use in human, therapeutic or diagnostic applications. BRAF蛋白是有丝分裂原活化的蛋白激酶/细胞外信号调节激酶途径蛋白。正常的B-Raf蛋白的功能是传递来自细胞膜的信号,在Ras-Raf-MEK-ERK信号转导调节途径中有着重要的作用。 BRAF是一种在癌细胞的生长和存活中起到关键作用的蛋白质,并且在大多数恶性黑素瘤患者和少数结肠癌、乳腺癌和肺癌患者中发生突变,目前BRAF也用于恶性黑素瘤和肿瘤的研究。 |
| 产品图片 | Paraformaldehyde-fixed, paraffin embedded (Rat testis); Antigen retrieval by boiling in sodium citrate buffer (pH6.0) for 15min; Block endogenous peroxidase by 3% hydrogen peroxide for 20 minutes; Blocking buffer (normal goat serum) at 37°C for 30min; Antibody incubation with (Phospho-B Raf (Thr598 + Ser601); B Raf) Polyclonal Antibody, Unconjugated (bs-12556R) at 1:400 overnight at 4°C, followed by a conjugated secondary (sp-0023) for 20 minutes and DAB staining.  Paraformaldehyde-fixed, paraffin embedded (Rat brain); Antigen retrieval by boiling in sodium citrate buffer (pH6.0) for 15min; Block endogenous peroxidase by 3% hydrogen peroxide for 20 minutes; Blocking buffer (normal goat serum) at 37°C for 30min; Antibody incubation with (Phospho-B Raf; B Raf) Polyclonal Antibody, Unconjugated (bs-12556R) at 1:400 overnight at 4°C, followed by a conjugated secondary (sp-0023) for 20 minutes and DAB staining. |
风险提示:丁香通仅作为第三方平台,为商家信息发布提供平台空间。用户咨询产品时请注意保护个人信息及财产安全,合理判断,谨慎选购商品,商家和用户对交易行为负责。对于医疗器械类产品,请先查证核实企业经营资质和医疗器械产品注册证情况。
 文献和实验
文献和实验Monitoring Oncogenic B-RAF-Induced Senescence in Melanocytes
The B-RAF kinase is a downstream effector of the RAS family of proto-oncogenes and is constitutively activated in the majority of human melanomas. The common oncogenic B-RAFV600E mutant cooperates with additional genetic lesions to transform
糖原磷酸化酶的不活化型。磷酸化酶a由于磷酸化酶磷酸酶( phosphorylase phosphatase)的作用脱磷酸而生成。在有 AMP( 5′ - 腺苷 - 磷酸)时活性。分子量约 19万,由二个相等的亚基构成。
细胞色素b563 cytochrome b563 亦称细胞色素 b6 。存在于高等植物至藻类的叶绿体中,与类囊体膜结合紧密。含有原正铁血红素,氧化还原 (β带)和 434nm(γ带或 So- ret带)。为发动光合磷酸化的环状电子传递系统的一个成分,可被光化系统Ⅰ所还原和氧化。
 技术资料
技术资料暂无技术资料 索取技术资料








